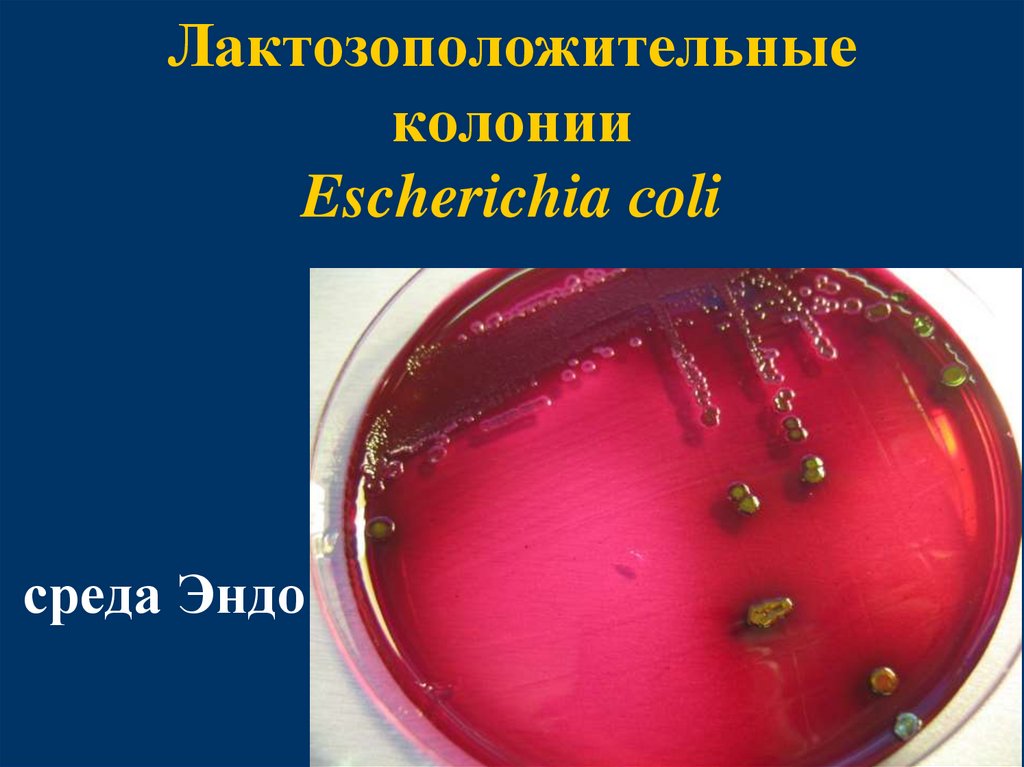
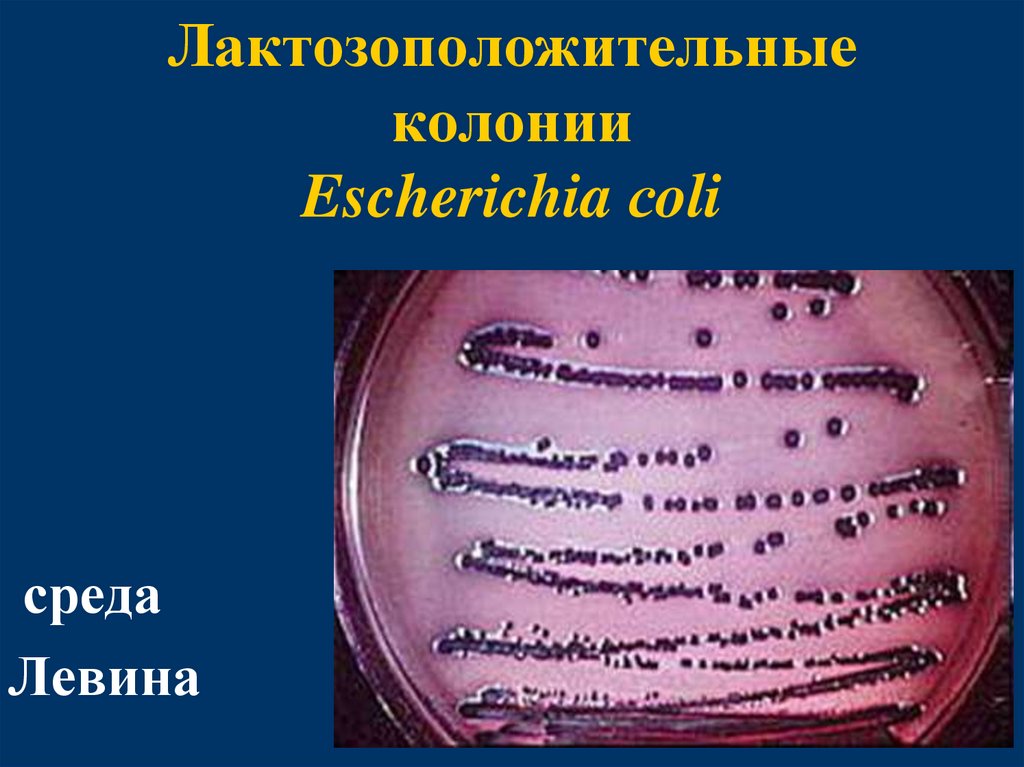
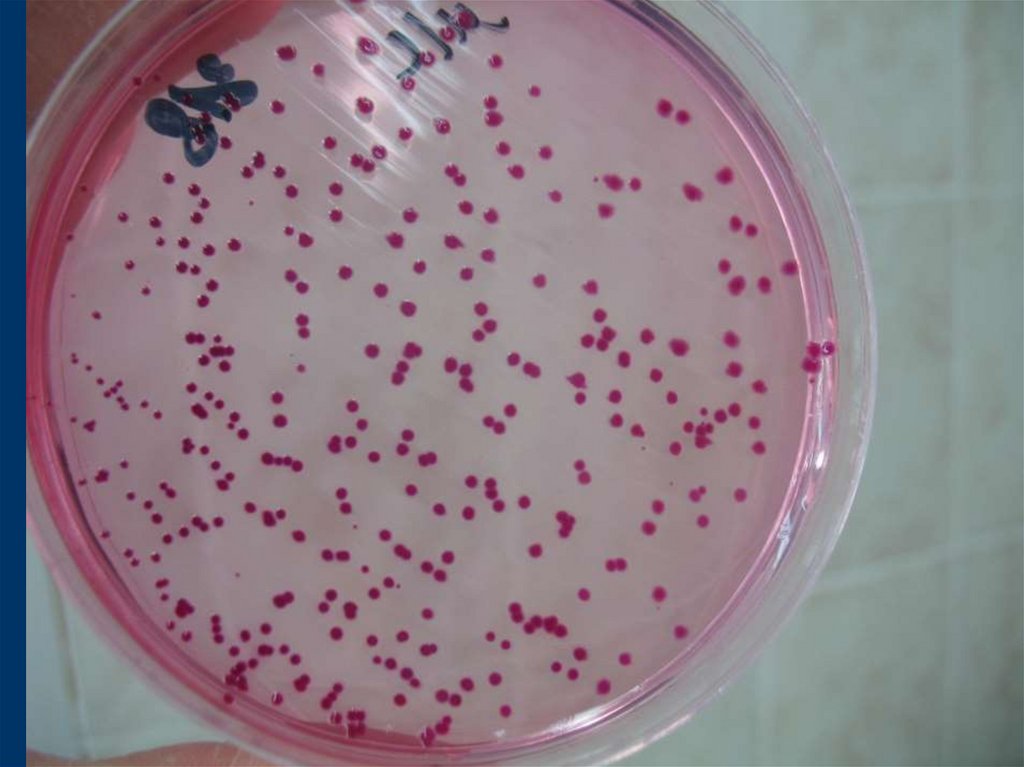
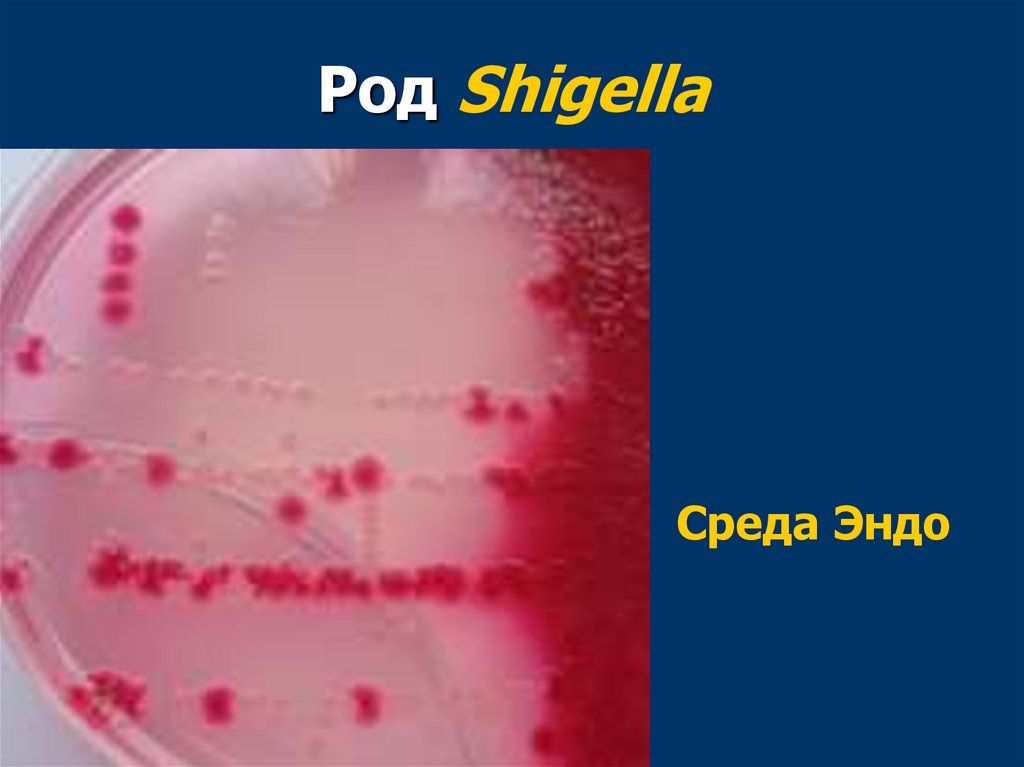

Similar presentations:
Семейство Еnterobacteriaceae
1. Семейство Еnterobacteriaceae
УРАЛЬСКИЙ ГОСУДАРСТВЕННЫЙ МЕДИЦИНСКИЙ УНИВЕРСИТЕТКАФЕДРА МИКРОБИОЛОГИИ, ВИРУСОЛОГИИ И ИММУНОЛОГИИ
Семейство Еnterobacteriaceae
2. Семейство Enterobacteriaceae
Заболевания у человекавызывают:
Escherichia, Shigella,
Salmonella, Klebsiella,
Proteus, Yersinia и другие
3. Род Escherichia
Кишечная палочка -Escherichia coli
Эти микроорганизмы
были открыты в 1885 г.
Теодором Эшерихом
4. Escherichia сoli
5. Escherichia сoli
6. Культивирование
Хорошо растут на простыхпитательных средах
Для определения сахаролитических
свойств применяют
дифференциально-диагностические
среды - среды Гисса, среда Эндо,
среда Левина, среда Плоскирева
7. Культивирование
Среды Эндо, Левина, Плоскиреваприменяются для
дифференцировки бактерий по их
способности ферментировать
лактозу.
Эти среды содержат питательный
агар, лактозу и индикатор,
изменяющий свой цвет в кислой
среде.
8. Культивирование
Колонии E.coli –лактозоположительные
Лактозоположительные колонии на
этих средах будут окрашенными
соответственно цвету индикатора:
на среде Эндо и среде Плоскирева в красный цвет с металлическим
блеском, на среде Левина - в черносиний.
9. Лактозоположительные колонии Escherichia сoli
среда Эндо10. Лактозоположительные колонии Escherichia сoli
средаЛевина
11. Культивирование
Лактозоотрицательные колонии(колонии бактерий, не
ферментирующих лактозу) будут бесцветными
12. Дифференцирующие признаки энтеробактерий на среде Клиглера
Среда Клиглера содержит:МПА
Глюкозу
Лактозу
Индикатор - феноловый красный (в
кислой среде желтеет)
Индикатор на Н2S (при выделении
чернеет)
13. Дифференцирующие признаки энтеробактерий на среде Клиглера
Принцип действия среды:ферментация глюкозы происходит только в
анаэробных условиях в глубине среды;
ферментация лактозы происходит в аэробных
условиях на поверхности среды (скоса);
при этом цвет индикатора меняется на
желтый (закисление среды);
о продукции сероводорода узнаем по
почернению среды.
14. Дифференцирующие признаки энтеробактерий на среде Клиглера
контрольЛактоза Глюкоза –
Н2S
-
Эшерихия
Лактоза - К+Г
Глюкоза – К+Г
Н2S
-
15. Дифференцирующие признаки энтеробактерий на среде Клиглера
ШигеллаЛактоза Глюкоза – К
Н2S
-
Сальмонелла
Лактоза Глюкоза – К+Г
Н2S +
16.
СредаКлиглера
Контроль
17. Антигенное строение
соматический О-антиген–
173 серологические группы,
капсульный К-антиген (А, В, L) –
97 вариантов,
жгутиковый Н-антиген
типовая специфичность – 57
типов.
–
18. Антигенное строение
Количество возможных комбинаций О-,К- и Н-антигенов превышает 2000.
Антигенную структуру отдельного
штамма E.coli характеризуют формулой,
в которую входят буквенно-цифровые
обозначения О-антигена, К-антигена и
Н-антигена.
Е. coli О111:К58:Н2
19.
Различают следующие группыкишечных палочек:
непатогенные (резидентные)
эшерихии;
эшерихии, вызывающие
внекишечные заболевания и
имеющие эндогенное
происхождение;
диареегенные эшерихии экзогенного
происхождения.
20. Роль в патологии
К патогенным относятся:возбудители парентеральных
эшерихиозов или
экстраинтестинальные
патогенные эшерихии,
диареегенные (интестинальные)
эшерихии.
21. Парентеральные эшерихиозы
К возбудителям парентеральныхэшерихиозов относятся:
уропатогенные эшерихии,
эшерихии, вызывающие менингиты
новорожденных,
ассоциированные с сепсисом
патогенные эшерихии.
22. Парентеральные эшерихиозы
Могут формироватьполирезистентные к антибиотикам
штаммы (за счет приобретения
R-плазмид), которые становятся
возбудителями ВБИ.
23.
Диареегенные(интестинальные) эшерихии
24. Диареегенные эшерихии
Подразделяются на 6 групп:энтеротоксигенные (ETEC);
энтероинвазивные (EIEC);
энтеропатогенные (EPEC);
энтерогеморрагические (EHEC);
энтероагрегативные (EAEC);
диффузно-адгерентные (диффузно-агрегативные)
(ДАКП).
25.
Энтеротоксигенные (ETEC)Поражают тонкий кишечник.
Продуцируют энтеротоксины LT и ST, синтез
которых обусловлен наличием плазмиды.
Клиническая картина инфекции сходна с
холерой: водянистая диарея, тошнота,
рвота, кишечные спазмы, лихорадка.
Вспышки водные, пищевые. Сезонность летняя.
Серогруппы: О6, О8, О15, О20, О25 и др.
26.
Энтероинвазивные (EIEC)Поражают клетки эпителия нижнего
отдела подвздошной и толстой кишки.
Являются возбудителями
дизентериеподобных заболеваний.
Сезонность летне-осенняя. Вспышки
пищевые, водные.
Серогруппы: О29, О124, О136, О143,
О144 и др.
27.
Энтеропатогенные (EPEC)Колонизируют поверхность слизистой
оболочки нижнего отдела тонкой кишки.
Заболевание характеризуется
продолжительной водянистой диареей,
рвотой, лихорадкой, симптомами
обезвоживания.
Инфекция передается контактно-бытовым
путем.
Преимущественно болеют дети в возрасте
до двух лет. Сезонность не выражена.
Серогруппы: О18, О44, О55, О86, О111,
О112.
28.
Энтерогеморрагические (EHEC)Поражают толстую кишку.
Развитие колита обусловлено
способностью ЕНЕС продуцировать
экзотоксины.
Сезонность летне-осенняя.
Поражаются все возрастные группы.
Наибольшее значение имеют
серогруппы: О26, О111, О157.
29. Гемолитико-уремический синдром
Клинико-гематологическийсимптомокомплекс, отличающийся
разнообразием этиологических
факторов и возникновением
тяжелейших нарушений в организме
человека.
Эта патология характеризуется
гемолизом эритроцитов, снижением
количества тромбоцитов в крови,
дисфункцией почек.
30. Гемолитико-уремический синдром
У пациентов с данной патологиейпоявляется:
боль в животе,
диарея с кровью,
бледность кожи, сыпь,
анурия,
симптомы поражения ЦНС, печени,
сердца.
31. Гемолитико-уремический синдром
Возбудителями гемолитико-уремическогосиндрома, связанного с диареей, являются
ЕНЕС, шигелла, стафилококк, а более редких
случаях — сальмонеллы, кампилобактерии,
клостридии.
Гемолитико-уремический синдром
обусловлен воздействием на организм
человека веротоксина (шигаподобный
токсин, цитотоксин), выделяемого
микроорганизмами.
32. Гемолитико-уремический синдром
Шигаподобный веротоксин вызывает гибельэндотелиоцитов, возникает воспаление,
гемолиз эритроцитов, адгезия и агрегация
тромбоцитов.
Микроциркуляторные расстройства приводят
к гипоксии внутренних органов.
У больных на фоне ОКИ происходит
воспаление клубочков почек, нарушение
фильтрационной функции, образование
очагов некроза.
33. Энтероагрегативные (ЭАКП)
ЭАКП колонизируют тонкий и толстый кишечник,вызывают секреторную диарею, поражают как
детей, так и взрослых.
Прикрепившись к эпителиальным клеткам, они
формируют агрегаты в виде кирпичной кладки.
После прикрепления ЭАКП стимулируют
выработку клетками слизи, что ведет к
образованию толстой слизистой биопленки.
К факторам патогенности ЭАКП относятся также
термостабильный энтеротоксин, гемолизин,
цитотоксин.
Не проникают в эпителиальные клетки.
34. третий тип секреторной системы бактерий
В настоящее время у Гр- микроорганизмовизвестны 5 систем секреции белковэффекторов (белков, выполняющих
определенную функцию) во внешнюю среду.
Например: эффекторные белки вызывают
реорганизацию цитоскелета клетки-хозяина,
что способствует проникновению бактерии в
эти клетки, а также вызывают различные
нарушения функций клеток, приводящие к
возникновению патологического процесса.
35. третий тип секреторной системы бактерий
Отличие третьего типа секреторной системы(ТТСС) состоит в следующем - активация секреции
происходит только при соприкосновении бактерии с
клеткой-мишенью и потому ТТСС относят к
контактной секреции.
Секреция белков – эффекторов происходит через
шприцеподобную структуру, состоящую из 20
различных по структуре белков.
Посредством ТТСС Yersinia pestis, Salmonella
enterica, Shigella flexneri, Escherichia coli, Chlamydia
trachomatis секретируют белки, играющие ведущую
роль в патогенезе вызываемых ими заболеваний.
36.
клетка-хозяинТТСС
наружная мембрана
бактериальной клетки
периплазматическое пространство
цитоплазматическая мембрана
бактериальной клетки
37.
Диареегенныеэшерихии, имеют
экзогенное
происхождение
38. Лабораторная диагностика
Основной метод диагностики –бактериологический (культуральный).
Исследуемым материалом может
служить гнойное отделяемое раны,
моча, кровь.
При острых кишечных инфекциях –
фекалии.
39.
40. Лабораторная диагностика
В связи с тем, что колонии патогенныхи непатогенных кишечных палочек на
указанных средах не отличаются,
принадлежность полученных колоний
к патогенным определяют с помощью
реакции агглютинации с
диагностическими сыворотками,
содержащих антитела к О или Кантигенам патогенных E.coli
41. Лабораторная диагностика
В реакции агглютинации проверяют 10лактозоположительных колоний.
Материал из каждой колонии берут
петлей так, чтобы часть ее осталась
для последующего пересева, если одна
из колоний дала положительную
агглютинацию, ее остаток пересевают
на среду Клиглера – с целью получения
чистой культуры.
42. Реакция агглютинации
43. Биохимическая активность
44. Реакция агглютинации с моновалентными сыворотнами
45.
ПоражениеСерогруппы
О-антиген
Энтеротоксигенные
(ЭТКП)
Энтеропатогенные
(ЭПКП)
Н-антиген
06, 08, 011, 015, Н4, Н7, Н9,
020, 025, 027,
Н11, Н12,
063, 078, 080,
Н19, Н20,
085, 0114,
Н21, Н28,
0115, 0126,
Н40
0128, 0139,
0148, 0153,
0159, 0166,
0167
018, 026, 044,
Н2, Н6, Н7,
055, 086, 011,
Н11, Н12,
0112, 0114,
Н14, Н18
0119, 0125,
0127, 0128,
К
46.
ПоражениеСерогруппы
О-антиген
Нанти
ген
Энтероинвазивные
(ЭИКП)
028, 029,
0112, 0115,
0124, 0135,
0136, 0143,
0144,
Н6, Н7,
Н8,
Н11
Энтерогеморагические
(ЭГКП)
0152, 0164,
0167 026,
К
47.
Мочевыводящиепути
01, 02, 04, 06, 07,
08, 09, 011,
018, 022, 025,
062, 075
К1, К2, К5,
К12, К13
Бактериемия
01, 02, 04, 06, 07,
08, 09, 011,
018, 022, 025,
075
К1, К2, К5,
К12, К15,
К23
Менингиты
01, 06, 07, 016,
018, 083
К1
48.
Род Shigella49. Род Shigella
Были описаны в1897 году
Киёси Шига
50. Род Shigella
Выделяют 4 вида:Sh. dysenteriae (15 серотипов);
Sh. flexneri (8 серотипов);
Sh. boydii (19 серотипов);
Sh. sonnei
51. Shigella dysenteriae
52.
Shigella dysenteriae53. Род Shigella
Факультативные анаэробы.К составу питательных сред не
требовательны.
Углеводы ферментируют до кислоты.
Не ферментируют лактозу (за
исключением Sh. sonnei, которая
способна ферментировать лактозу
замедленно, в течение 48 - 120 часов).
54. Род Shigella
Среда Эндо55. Дифференцирующие признаки энтеробактерий на среде Клиглера
контрольЛактоза Глюкоза –
Н2S
-
Шигелла
Лактоза Глюкоза – К
Н2S
-
56. Дизентерия
Источник инфекции - человек,больной или бактерионоситель.
Механизм передачи инфекции –
фекально-оральный
Пути передачи:
алиментарный (Sh. sonnei )
водный (Sh. flexneri )
контактно-бытовой (Sh. dysenteriaе)
57. Патогенез дизентерии
Заражение при дизентерии происходит толькочерез рот.
Из ротовой полости возбудители попадают в
желудок.
Под действием соляной кислоты,
пищеварительных ферментов возбудитель
гибнет, освобождая эндотоксин.
Далее шигеллы попадают в дистальные
отделы кишечника, где активно
размножаются.
58. Патогенез дизентерии
Взаимодействие шигелл со слизистойоболочкой кишечника начинается с
прикрепления микроорганизмов к клеткам
эпителия, обусловленного вначале
адсорбцией, затем адгезией.
Проникшие внутрь клеток кишечника
шигеллы активно размножаются.
Иммунитет при дизентерии является видо- и
даже типоспецифическим,
продолжительность его может колебаться от
1-3 месяцев до 2 лет.
59. Лабораторная диагностика
основной метод диагностики бактериологическийисследуемый материал испражнения
материал засевают на
дифференциально-диагностические
питательные среды с лактозой
(среда Плоскирева, Эндо, Левина)
60. Лабораторная диагностика
для выделения чистой культурыотбирают лактозонегативные
(бесцветные) колонии, которые
пересевают на агар Клиглера)
для выявления бактерионосителей
используют серологический метод
(РНГА)
61. Профилактика
Плановая специфическая профилактика при шигеллезах непроводится.
По эпидемическим показаниям (работа в баклабораториях, в
сфере общественного питания) используется вакцина
Шигеллвак.
Она представляет собой раствор липополисахарида S. sonnei,
очищенного физико-химическими методами.
Через 2-3 недели после введения вакцины обеспечивается
невосприимчивость к инфекции в течение 1 года.
Вакцина вводится подкожно или внутримышечно
однократно.
Возможна ежегодная ревакцинация.
Для экстренной профилактики дизентерии в очагах
инфекции применяют дизентерийный бактериофаг.
62. Профилактика
Неспецифическая профилактикапредусматривает раннее выявление
больных и бактерионосителей,
соблюдение санитарно-гигиенических
правил приготовления, хранения и
реализации пищевых продуктов,
контроль качества питьевой воды,
соблюдение правил личной гигиены,
санитарно-просветительную работу
среди населения.
63.
Сальмонеллы64.
Были открыты в1885 году
американским
ветеринарным
врачом
Д. Сальмоном
65.
Сальмонеллы - это обширнаягруппа бактерий, сходных по
морфологическим,
тинкториальным и культуральным
свойствам, но различающихся по
биохимическим и антигенным
характеристикам
66. семейство Enterobacteriaceae
Согласно современной классификации, основаннойна строении ДНК, род Salmonella состоит из двух
видов - вида S. enterica и вида S. bongori.
В состав вида S. enterica включены все сальмонеллы,
являющиеся возбудителями заболеваний человека и
теплокровных животных.
67. В зависимости от источника инфицирования выделяют:
брюшной тиф и паратифы (возбудители:Salmonella typhi, S. paratyphi A, S.
paratyphi В)
сальмонеллезы (возбудители:
сальмонеллы животного происхождения,
бипатогенные –
S. typhimurium и т.д.)
68. Род Salmonella
69. Род Salmonella
70.
Тинкториальные свойства(окраска по Граму)
71.
Возбудителибрюшного тифа и паратифов
72.
Salmonella enterica subsp. enterica serovarTyphi
Salmonella enterica subsp. enterica serovar
Paratyphi A;
Salmonella enterica subsp. enterica serovar
Paratyphi B
subsp. (сокр. от ла. subspecies) — подвид
73.
Salmonella Typhi,S. Рaratyphi A,
S. Рaratyphi В
74. Культуральные свойства
Факультативные анаэробыПодвижные
Растут на простых питательных
средах – колонии - S формы
Дифференциально-диагностические
среды - Эндо, Левина, Плоскирева –
колонии - лактозоотрицательные
75. Культуральные свойства
Среды обогащения (жидкиеселективные питательные среды для
выделения сальмонелл): среда
Мюллера, селенитовая среда,
магниевая среда, желчная
среда, среда Рапопорт
76. Культуральные свойства
Дифференциально-диагностическиесреды – висмут-сульфит агар
Колонии:
черные (S. Typhi),
темно-зеленые (S. Paratуphi A),
черные с валиком (S. Paratуphi B)
77. Род Salmonella
висмутсульфитагар
78.
висмут-сульфит агарS. Typhi
S. Paratуphi B
79. Среда Клиглера
Лактозаглюкоза
Н2S
S.Typhi
S. Paratуphi А
S. Paratуphi B
80. Антигенное строение
Соматический О-антигенЖгутиковый Н-антиген
Капсульный К-антиген
Vi-антиген (Аг-вирулентности)
81. схема Кауфмана-Уайта (1934)
По О-антигену - 50серологических групп
По Н-антигену - на
серологические варианты:
- специфическая фаза - (a,b…),
- неспецифическая фаза - (1,2…)
82. Антигенная структура Классификация по Кауфману-Уайту
ГруппаНаименование
Соматич
еский
(О) Антиген
Жгутико
вый (H)
антиген
Фаза 1
Жгутико
вый (H)
антиген
Фаза 2
О2
A
S.paratyphi A
1,2,12
a
-
О4
B
S. paratyphi B
1,4,5,
12
b
1,2
О7
C1
S.Paratyphi C
6,7,Vi
C
1,5
О9
D
S.typhi
S.enteritidis
S.dublin
S.panama
9,12,Vi
1,9,12
1,9,12
1,9,12
d
g,m
g,p
iv
1,5
Идентифи
кация
абсорбиро
ванной Оантисывор
откой
83. Брюшной тиф
Salmonella TyphiАнтропонозная инфекция
Источник инфекции - человек -
больной или носитель
Механизм передачи инфекции -
фекально-оральный
Путь - водный
84. Клинические проявления
Брюшной тиф - остраяинфекционная болезнь,
проявляющаяся
продолжительной лихорадкой,
высыпаниями на коже,
кишечным расстройством и
тяжелой интоксикацией.
85. Факторы патогенности
Фимбрии и белки наружноймембраны – факторы адгезии;
Эндотоксин (ЛПС);
Антифагоцитарный фактор - Vi
антиген
86. Патогенез брюшного тифа
1.Возбудитель брюшного тифа с пищейили водой попадает в желудок.
Под действием желудочного сока
часть бактерий погибает, а
оставшиеся клетки проникают в
тонкий кишечник.
Для развития заболевания
достаточно 100 тыс. микробных
клеток.
87. Патогенез брюшного тифа
2. Адгезия сальмонелл на клетках кишечникаосуществляется с помощью пилей
(ворсинок).
Проникновение сальмонелл в стенку
кишечника происходит через М-клетки.
Затем сальмонеллы размножаются и
транспортируются в подслизистый слой, где
захватываются макрофагами.
88. Патогенез брюшного тифа
3. Внутри макрофагов сальмонеллыразмножаются и попадают в пейеровы
бляшки, вызывая их воспаление – это
первичный очаг инфекции.
Защиту сальмонелл от фагоцитоза
обеспечивает Vi-АГ.
89. Патогенез брюшного тифа
4. Из пейеровых бляшек сальмонеллы с током лимфыпереносятся в лимфатические узлы, где
размножаются и поступают в кровь, обусловливая
первичную бактериемию.
Это происходит в конце инкубационного периода, т.
е. через 10-14 суток после инфицирования.
В этот период возбудитель обнаруживается в крови
больного.
90. Патогенез брюшного тифа
5. В кровеносном русле частьсальмонелл разрушается. При этом
высвобождается эндотоксин, который
вызывает лихорадку и развитие
тифозного статуса.
При тяжелом течении заболевания
может развиться инфекционнотоксический шок.
91. Патогенез брюшного тифа
6 Сальмонеллы разносятся по организму, оседают в.
печени, селезенке, костном мозге, почках, что
приводит к поступлению в кровь большого
количества сальмонелл (вторичная бактериемия).
Из печени через желчные протоки с током желчи
сальмонеллы возвращаются в кишечник.
В результате этого наступает реинфекция тонкого
кишечника (вторая неделя болезни).
92. Патогенез брюшного тифа
7. Из кишечника часть сальмонеллвыводится с калом, а другая часть
бактерий вновь внедряется в пейеровы
бляшки.
Повторное внедрение сальмонелл в
сенсибилизированные пейеровы
бляшки приводит к развитию в них
воспаления, их некрозу и изъязвлению.
93. Патогенез брюшного тифа
8. На третьей – четвертой неделе встенке кишки формируются глубокие
язвы.
При поражении стенки сосуда
возникает кровотечение.
На пятой-шестой неделе происходит
заживление язв.
94. Исход заболевания
В большинстве случаев бактерииполностью элиминируются из
организма.
Однако в 3-5% случаев формируется
бактерионосительство, при котором
сальмонеллы остаются в костном мозге
или желчном пузыре.
Брюшной тиф может сопровождаться
рецидивами и осложнениями. Наиболее
опасным осложнением является
прободение стенки кишечника и
развитие перитонита.
95. Иммунитет
После перенесенного брюшноготифа развивается напряженный и
длительный (пожизненный)
иммунитет.
Повторные заболевания возникают
редко.
96. Лабораторная диагностика
Первая неделя болезни -гемокультура
Вторая неделя - серодиагностика
(реакция агглютинации Видаля)
Третья неделя - копро- и
уринокультура
97.
ДИАГНОСТИКА БРЮШНОГО ТИФАI неделя
Материал:
кровь - гемокультура
1. Среды накопления (желчный бульон)
2. Среды дифференциальнодиагностические (Левина, Плоскирева,
висмут-сульфид агар)
Лактоза «-» колонии
3. Получение чистой культуры - среда
Олькеницкого
4. Биохимическая активность – среда
Клиглера
5. Реакции агглютинации с антисыворотками
О - серогруппа D - О -9, Vi, Н - d
98. Антигенная структура Классификация по Кауфману-Уайту
ГруппаНаименование
Соматич
еский
(О) Антиген
Жгутико
вый (H)
антиген
Фаза 1
Жгутико
вый (H)
антиген
Фаза 2
О2
A
S.paratyphi A
1,2,12
a
-
О4
B
S. paratyphi B
1,4,5,
12
b
1,2
О7
C1
S.Paratyphi C
6,7,Vi
C
1,5
О9
D
S.typhi
S.enteritidis
S.dublin
S.panama
9,12,Vi
1,9,12
1,9,12
1,9,12
d
g,m
g,p
iv
1,5
Идентифи
кация
абсорбиро
ванной Оантисывор
откой
99.
ДИАГНОСТИКА БРЮШНОГО ТИФАII неделя
Материал: сыворотка крови серодиагностика
Реакция агглютинации Видаля
(реакция развернутой
агглютинации)
Определение титра антител в
сыворотке крови больного к О- и Н
-АГ
100. Реакция агглютинации Видаля (реакция развернутой агглютинации)
101.
ДИАГНОСТИКА БРЮШНОГО ТИФАIII неделя
Материал: фекалии, моча,
желчь, соскоб с розеол
копро- , уринокультура, при
исследовании желчи биликультура
102. Лабораторная диагностика
При подозрении набрюшнотифозное носительство
исследуют сыворотку крови на
наличие антител к Vi-антигену с
помощью реакции непрямой
гемагглютинации (РНГА) с
эритроцитарным диагностикумом к
Vi-антигену
103. Специфическая профилактика
Vi-полисахаридная вакцинаВ состав данной вакцины входит
очищенный Vi-АГ, полученный из S.
typhi.
Вакцина вводится подкожно или
внутримышечно однократно детям с 2летнего возраста и взрослым
104.
Сальмонеллы животногопроисхождения
(бипатогенные сальмонеллы)
105.
Сальмонеллы животногопроисхождения
(бипатогенные сальмонеллы)
S. typhimurium, S. choleraesuis и
т.д.
106. Сальмонеллы животного происхождения
Первичным источником являются животные:крупный рогатый скот, свиньи,
водоплавающие птицы, куры, грызуны
Заражение связано с употреблением:
мяса - до 70 – 75%,
птицепродуктов – до 10%,
молочных продуктов – около 10%,
рыбы – около 3 – 5% случаев
Человек (больной, особенно стертой формой
сальмонеллеза, или бактерионоситель).
107. Сальмонеллы животного происхождения
Механизм передачи –фекально-оральный
Пути –
алиментарный,
водный,
контактно-бытовой.
108. Факторы патогенности
У бипатогенных сальмонелл имеются:факторы адгезии и колонизации,
факторы инвазии,
эндотоксин,
экзотоксины:
термолабильные и термостабильные
энтеротоксины типа LT и ST;
шигаподобные цитотоксины.
109.
110. Клинические формы
гастроинтестинальнаягипертоксическая
остролихорадочная
тифоподобная
септическая
субклиническая форма
носительство
111. профилактика
Специфическая профилактика неприменяется.
Неспецифическая профилактика:
ветеринарно-санитарные мероприятия–
предупреждение сальмонеллезов среди
животных и птиц;
санитарно-гигиенические – защиты
пищевых продуктов от заражения;
противоэпидемические – выявление
носителей, больных, их лечение.
112. Дома
Другие грамотрицательныекишечные бактерии.
Campylobacter spp., Vibrio cholerae,
Yersinia enterocolitica, Yersinia
pseudotuberculosis.

medicine
medicine








